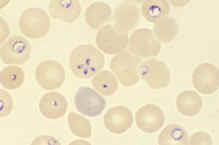

Babesiosis
Babesiosis
Microbial Diseases A to Z | Disease Home Page | Bio 406 Home Page | MicroWorld |
Babesiosis
Babesiosis Babesiosis is a vector-borne zoonotic disease caused by the protozoan Babesia microti and others. Most infections are mild or asymptomatic, and anemia is the main cause of symptoms. It must be distinguished from malaria.